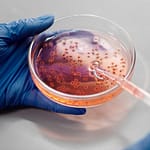

தற்போதைய ஆய்வின் முக்கிய நோக்கம், செயற்கை நரம்பியல் வலையமைப்பு (ANN – Artificial Neural Network) மாதிரிகள் முதுகெலும்புடன் கூடிய நெல் விளைச்சலை பல்வேறு கால நிலைகளில் திறம்பட கணிக்க முடியுமா என்பதை ஆராய்வது; நிலம் சார்ந்த மழை, நிலம் சார்ந்த வானிலை மாறிகள் மற்றும் வரலாற்று மகசூல் தரவு ஆகியவை முக்கிய காரணிகளாகும். பின் பரப்புதல் வழிமுறை ஒரு யூனிட்டின் செயல்பாட்டு நிலை மாற்றப்பட்டதால் பிழை வீதத்தைப் பயன்படுத்தி எதிர்பார்க்கப்படும் ஒவ்வொரு எடையையும் கணக்கிடும். பயிற்சியின் போது மாதிரியில் உள்ள பிழைகள் மீண்டும் பரப்புதலின் போது தீர்க்கப்பட்டன. நெல் மகசூல் கணிப்பு மழை, மண் ஈரப்பதம், சூரிய கதிர்வீச்சு, எதிர்பார்க்கப்படும் கார்பன், உரங்கள், பூச்சிக்கொல்லிகள் மற்றும் செயற்கை நரம்பியல் வலையமைப்புகளைப் பயன்படுத்தி பதிவுசெய்யப்பட்ட நீண்டகால நெல் மகசூல் போன்ற பல்வேறு அளவுருக்களை எடுத்தது. சோதனைத் தொகுப்பில் உள்ள R2 மதிப்பு 93% எனக் கண்டறியப்பட்டது மற்றும் கொடுக்கப்பட்ட தரவுத் தொகுப்பிற்கு நெல் விளைச்சலை சிறப்பாகக் கணிக்க முடிந்தது என்பதை அது காட்டியது.
ANN மாதிரி 0.25 மற்றும் 0.5 கற்றல் விகிதங்களுடன் சோதிக்கப்பட்டது. முதல் அடுக்கில் மறைக்கப்பட்ட அடுக்குகளின் எண்ணிக்கை 50 மற்றும் இரண்டாவது மறைக்கப்பட்ட அடுக்கில் 30. இதிலிருந்து, R2 சோதனை மதிப்பு 0.97 ஆகும். ANN மாடலுடன் கூடிய அவதானிப்புகள்
- சோதனை தொகுப்புக்கான சிறந்த முடிவு 98 இன் R2 மதிப்பு,
- முதல் அடுக்கில் 50 நியூரான்கள் மற்றும் இரண்டாவது ஒன்றில் 30 நியூரான்கள் ஆகிய இரண்டு மறைக்கப்பட்ட அடுக்குகள், கற்றல் வீதம் 25 ஆக இருந்தது. இந்த அனைத்து அமைப்புகளிலும், நெல் பயிரிலிருந்து அதிகபட்ச மகசூல் சாத்தியமாகும்.
References: